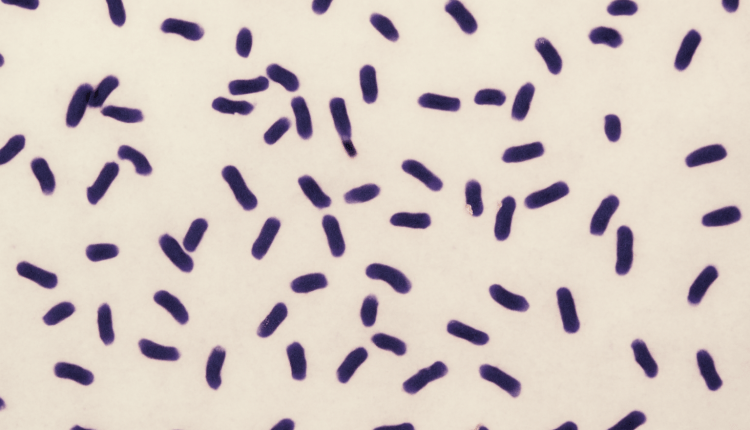

RKI warnt vor tödlichen Hib-Infektionen in Hamburg/RKI’den Hamburg’da Hib Bakterisi Uyarısı
Robert Koch-Institut (RKI) meldet seit Oktober 2024 einen deutlichen Anstieg lebensbedrohlicher Infektionen durch Haemophilus influenzae Typ b (Hib) in Hamburg. Betroffen sind vor allem drogengebrauchende und wohnungslose Menschen. Drei Todesfälle wurden bereits bestätigt. Das RKI informiert in seinem „Infoblatt: Lebensbedrohliche Erkrankungen durch Hib-Bakterien in Hamburg“ über Krankheitsverlauf, Übertragungswege und Schutzmöglichkeiten wie Impfungen. Zugleich veröffentlichten RKI und das Bundesinstitut für Arzneimittel und Medizinprodukte (BfArM) aktualisierte Kriterien für Reserveantibiotika gegen multiresistente Erreger. Zudem stellten RKI-Forschende eine neue Massenspektrometrie-Methode vor, die hunderte Viren in Patientenproben schnell identifizieren kann, und kündigten die Ausschreibung von neun neuen Konsiliarlaboren zur Stärkung der Labordiagnostik an.
RKI’den Hamburg’da Hib Bakterisi Uyarısı
Robert Koch Enstitüsü (RKI), Hamburg’da Ekim 2024’ten bu yana Haemophilus influenzae Tip b (Hib) bakterisinin neden olduğu ağır enfeksiyon vakalarının arttığını bildirdi. Menenjit ve kan zehirlenmesi gibi hayati tehlike oluşturan hastalıklar sonucu üç kişi yaşamını yitirdi. Vakaların çoğunun uyuşturucu kullanan ve evsiz kişiler arasında görüldüğü belirtildi. RKI, “Infoblatt: Lebensbedrohliche Erkrankungen durch Hib-Bakterien in Hamburg” başlıklı bilgilendirme notunda hastalık hakkında detaylı bilgi ve korunma yollarını paylaştı.
Hib Bakterisine Karşı Aşının Önemi
Hib bakterisi, özellikle aşısız kişilerde hızlı ilerleyen ve ölümcül olabilen enfeksiyonlara yol açabiliyor. RKI, risk grubundaki kişilerin ve yakın temaslıların aşı ile korunmasının hayati önem taşıdığını vurguluyor.
Rezerv Antibiyotik Listesi Güncellendi
Almanya’da enfeksiyon hastalıklarıyla mücadelede antibiyotik direncine karşı adımlar atılıyor. RKI ve Federal İlaç ve Tıbbi Ürünler Enstitüsü (BfArM), §35a SGB V kapsamında “rezerv antibiyotik” tanımını ve bu ilaçların hangi çok dirençli bakterilere karşı kullanılacağını belirleyen listeyi güncelledi.
Yeni Tanı Yöntemi ile Virüsler Daha Hızlı Tespit Ediliyor
RKI araştırmacıları, kütle spektrometrisi kullanarak hasta örneklerinde aynı anda yüzlerce farklı virüsü tespit edebilen yeni bir tanı yöntemi geliştirdi. “vPro-MS” adı verilen bu teknik, mevcut yöntemlere kıyasla çok daha hızlı sonuç veriyor. Bulgular, Nature Communications dergisinde yayımlandı.
Laboratuvar Kapasitesi Artırılıyor
Enstitü, tanı kapasitesini güçlendirmek amacıyla 9 yeni konsilyum laboratuvarı için başvuru sürecini başlattı.
#RKI #Hamburg #Hib #HibBakterien #Infektion #Meningitis #Sepsis #Impfung #AntibiotikaResistenz #ReserveAntibiotika #Massenspektrometrie #Labor #Gesundheit #Deutschland #HibBakterisi #Enfeksiyon #Menenjit #Sepsis #Aşı #AntibiyotikDirenci #RezervAntibiyotik #KütleSpektrometrisi #Laboratuvar #Sağlık #Almanya

Kommentare sind geschlossen, abertrackbacks und Pingbacks sind offen.